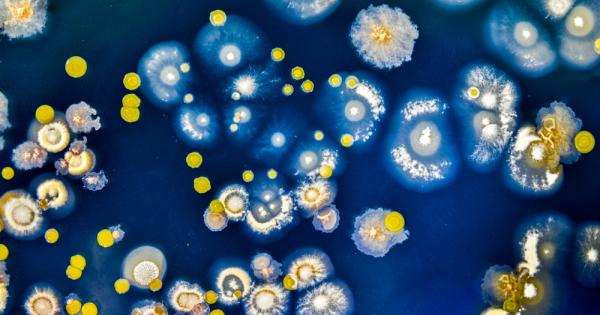
Не им е лесно на бактериите Не стига че имунните

... им крие голям потенциал. Най-малкото за терапия с клонирани антитела от прилепи.Последвайте ни във и Вече може да ни гледате и в Намерете ни в
Тайните Имунната - Новини
Не им е лесно на бактериите Не стига че имунните
...... антибиотици, които да се справят по-ефективно с лошите бактерии, както и стимуланти, които да продължат живота на добрите, каквито например се използват в хранителната промишленост.
Лятото е към края си наближава есента а с нея
...... Този чай ще ви изпоти и простудата ще мине лесно и бързо. Какви са другите две ползи от черния бъз четете в най-полезния сайт Zdrave.to.